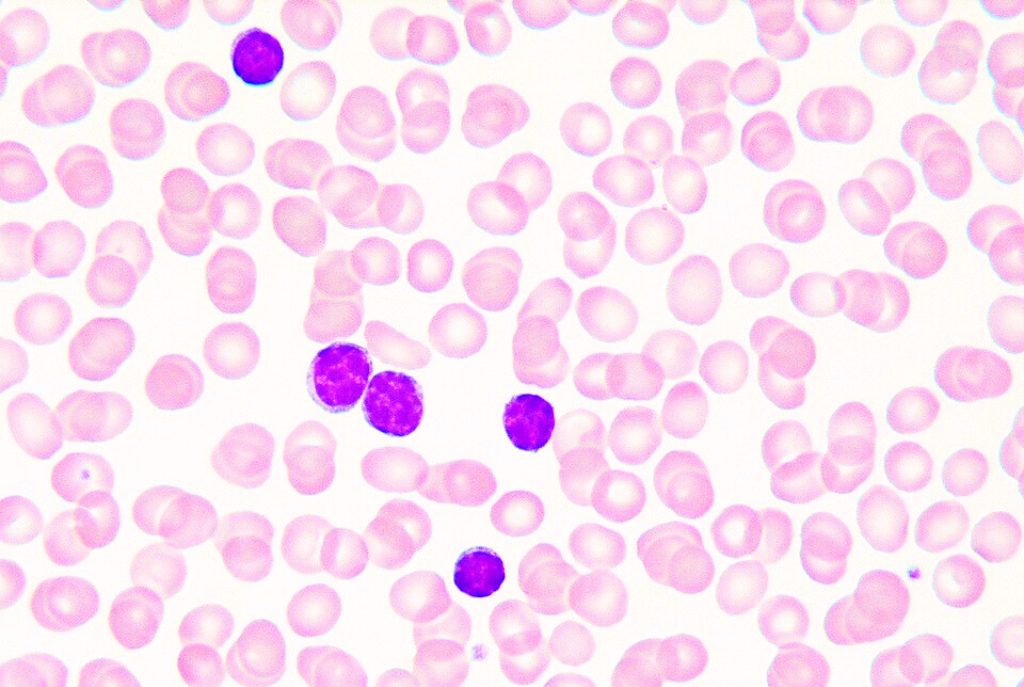
Link Preview Image

· Researchers state that post-vaccine syndrome is characterized by persistent immune dysregulation & issues with blood coagulation.
-
· Two studies on potential biomarkers for #MECFS were published this month
· Stellate ganglion blocks, a procedure where an anesthetic is injected into nerves in the neck, may help reduce the severity of some symptoms of #LongCOVID and ME
· An observational study is recruiting 40 people in Boston, Massachusetts to test for defects of air and blood flow in the lungs in people with Long COVID
Research updates, July 29 - The Sick Times
Two studies on potential biomarkers for myalgic encephalomyelitis (ME) were published this month. Plus, new studies about stellate ganglion blocks.

The Sick Times - Chronicling the Long Covid crisis (thesicktimes.org)
· A drug originally developed for celiac disease was found to be safe and effective in treating a post-COVID syndrome in children
· “Dormant cancer cells are like the embers left in an abandoned campfire, and respiratory viruses are like a strong wind that reignites the flames,” said one of the authors of a new study in Nature
· An upcoming at-home clinical trial program for #LongCOVID, run by Scripps Research, is seeking participants
Research updates, August 5 - The Sick Times
A drug originally developed for celiac disease was found to be safe and effective in treating a post-COVID syndrome in children, according to a new paper published in Science Translational Medicine.

The Sick Times - Chronicling the Long Covid crisis (thesicktimes.org)
-
· A drug originally developed for celiac disease was found to be safe and effective in treating a post-COVID syndrome in children
· “Dormant cancer cells are like the embers left in an abandoned campfire, and respiratory viruses are like a strong wind that reignites the flames,” said one of the authors of a new study in Nature
· An upcoming at-home clinical trial program for #LongCOVID, run by Scripps Research, is seeking participants
Research updates, August 5 - The Sick Times
A drug originally developed for celiac disease was found to be safe and effective in treating a post-COVID syndrome in children, according to a new paper published in Science Translational Medicine.

The Sick Times - Chronicling the Long Covid crisis (thesicktimes.org)
· People with myalgic encephalomyelitis (#MECFS) have significant genetic differences in their DNA
· A very small clinical trial of the infusion drug BC 007 published in eClinicalMedicine found “significant improvement” in fatigue in people with #LongCOVID
· A phase 2 clinical trial testing the monoclonal antibody sipavibart is recruiting in Fort Lauderdale, Florida
Research updates, August 12 - The Sick Times
People with myalgic encephalomyelitis (ME) have significant genetic differences in their DNA, according to a preprint shared this week from the DecodeME study.

The Sick Times - Chronicling the Long Covid crisis (thesicktimes.org)
-
· People with myalgic encephalomyelitis (#MECFS) have significant genetic differences in their DNA
· A very small clinical trial of the infusion drug BC 007 published in eClinicalMedicine found “significant improvement” in fatigue in people with #LongCOVID
· A phase 2 clinical trial testing the monoclonal antibody sipavibart is recruiting in Fort Lauderdale, Florida
Research updates, August 12 - The Sick Times
People with myalgic encephalomyelitis (ME) have significant genetic differences in their DNA, according to a preprint shared this week from the DecodeME study.

The Sick Times - Chronicling the Long Covid crisis (thesicktimes.org)
· A new preprint from the National Institutes of Health (NIH) RECOVER study found that #COVID19 reinfections may increase risk of #LongCOVID by about 35%
· A new review article in Ageing Research Reviews found that persistent infections from viruses, bacteria, fungus, and parasites can accelerate human aging
· A new Long COVID clinical trial to test the immunotherapy drug Anktiva was announced this week by the Chan Soon-Shiong Institute for Medicine
Research updates, August 19 - The Sick Times
A new preprint from the National Institutes of Health (NIH) RECOVER study found that COVID reinfections may increase the risk of Long COVID by about 35%.

The Sick Times - Chronicling the Long Covid crisis (thesicktimes.org)
-
· A new preprint from the National Institutes of Health (NIH) RECOVER study found that #COVID19 reinfections may increase risk of #LongCOVID by about 35%
· A new review article in Ageing Research Reviews found that persistent infections from viruses, bacteria, fungus, and parasites can accelerate human aging
· A new Long COVID clinical trial to test the immunotherapy drug Anktiva was announced this week by the Chan Soon-Shiong Institute for Medicine
Research updates, August 19 - The Sick Times
A new preprint from the National Institutes of Health (NIH) RECOVER study found that COVID reinfections may increase the risk of Long COVID by about 35%.

The Sick Times - Chronicling the Long Covid crisis (thesicktimes.org)
· Metformin may help reduce the risk of #LongCOVID, according to two new studies
· A Phase 2 clinical trial is studying the drug vidofludimus calcium (IMU-838) for Long COVID
· The National Institutes of Health’s second RECOVER-Treating Long COVID workshop is happening next week, September 9–10
Research updates, September 2 - The Sick Times
Metformin may help reduce the risk of Long COVID, according to two new studies. One large study from the United Kingdom found that it reduced the rate of Long COVID in “obese and overweight” people by 63% percent.

The Sick Times - Chronicling the Long Covid crisis (thesicktimes.org)
-
· Metformin may help reduce the risk of #LongCOVID, according to two new studies
· A Phase 2 clinical trial is studying the drug vidofludimus calcium (IMU-838) for Long COVID
· The National Institutes of Health’s second RECOVER-Treating Long COVID workshop is happening next week, September 9–10
Research updates, September 2 - The Sick Times
Metformin may help reduce the risk of Long COVID, according to two new studies. One large study from the United Kingdom found that it reduced the rate of Long COVID in “obese and overweight” people by 63% percent.

The Sick Times - Chronicling the Long Covid crisis (thesicktimes.org)
· A medium sized study in Saudi Arabia found that 29% of participants who were infected with SARS-CoV-2 developed #LongCOVID
· In a small case series, a combination of three antivirals was effective in improving symptoms in participants with Long COVID, according to a new preprint
· The Food and Drug Administration (FDA) accepted the drug application of a potential oral therapy for the prevention of #COVID19 following exposure
Research updates, September 9 - The Sick Times
A large study in Saudi Arabia found that 29% of participants who were infected with SARS-CoV-2 developed Long COVID. “This finding is consistent with the higher prevalence estimates reported globally and highlights the long-term burden of post-acute COVID-19 symptoms,” the authors of the study, published in BMC Infectious Diseases, wrote.

The Sick Times - Chronicling the Long Covid crisis (thesicktimes.org)
-
· A medium sized study in Saudi Arabia found that 29% of participants who were infected with SARS-CoV-2 developed #LongCOVID
· In a small case series, a combination of three antivirals was effective in improving symptoms in participants with Long COVID, according to a new preprint
· The Food and Drug Administration (FDA) accepted the drug application of a potential oral therapy for the prevention of #COVID19 following exposure
Research updates, September 9 - The Sick Times
A large study in Saudi Arabia found that 29% of participants who were infected with SARS-CoV-2 developed Long COVID. “This finding is consistent with the higher prevalence estimates reported globally and highlights the long-term burden of post-acute COVID-19 symptoms,” the authors of the study, published in BMC Infectious Diseases, wrote.

The Sick Times - Chronicling the Long Covid crisis (thesicktimes.org)
· An estimated 36% of people with a documented SARS-CoV-2 infection worldwide have experienced #LongCOVID, according to a new systematic review
· New funding will help advance a potential low-cost diagnostic test for myalgic encephalomyelitis (#ME)
· The SPEAR study group has proposed a potential Long COVID clinical trial with the company’s next-generation monoclonal antibody, VYD2311
Research updates, September 16 - The Sick Times
An estimated 36% of people with a documented SARS-CoV-2 infection worldwide have experienced Long COVID, according to a new systematic review that synthesized over 400 studies.

The Sick Times - Chronicling the Long Covid crisis (thesicktimes.org)
-
· An estimated 36% of people with a documented SARS-CoV-2 infection worldwide have experienced #LongCOVID, according to a new systematic review
· New funding will help advance a potential low-cost diagnostic test for myalgic encephalomyelitis (#ME)
· The SPEAR study group has proposed a potential Long COVID clinical trial with the company’s next-generation monoclonal antibody, VYD2311
Research updates, September 16 - The Sick Times
An estimated 36% of people with a documented SARS-CoV-2 infection worldwide have experienced Long COVID, according to a new systematic review that synthesized over 400 studies.

The Sick Times - Chronicling the Long Covid crisis (thesicktimes.org)
· Two recent studies found limitations of the drug Paxlovid for protection from #LongCOVID, contrasting prior studies that suggested the antiviral drug might help prevent the disease
· Long COVID may increase menstrual bleeding, according to a new survey study published in Nature Communications
· A new clinical trial is testing the supplement Mitoquinone in combination with “exercise rehabilitation” (which may be detrimental) for Long COVID
Research updates, September 23 - The Sick Times
Two recent studies found limitations of the drug Paxlovid for protection from Long COVID, contrasting prior studies that suggested the antiviral drug might help prevent this disease.

The Sick Times - Chronicling the Long Covid crisis (thesicktimes.org)
-
· Two recent studies found limitations of the drug Paxlovid for protection from #LongCOVID, contrasting prior studies that suggested the antiviral drug might help prevent the disease
· Long COVID may increase menstrual bleeding, according to a new survey study published in Nature Communications
· A new clinical trial is testing the supplement Mitoquinone in combination with “exercise rehabilitation” (which may be detrimental) for Long COVID
Research updates, September 23 - The Sick Times
Two recent studies found limitations of the drug Paxlovid for protection from Long COVID, contrasting prior studies that suggested the antiviral drug might help prevent this disease.

The Sick Times - Chronicling the Long Covid crisis (thesicktimes.org)
· Researchers in Spain assessed over 190,000 participants, found that #LongCOVID prevalence was three to 10 times higher in individuals with three or more reported infections
· A new RECOVER study published in JAMA found that olfactory dysfunction, or changes to sense of smell, occurred in people after SARS-CoV-2 infection
· A behavioral trial at Columbia University (LONG-CALM) is assessing a vague “mindfulness intervention” for Long COVID
Research updates, September 30 - The Sick Times
Researchers in Spain assessed over 190,000 participants, using data from a public health research network, in a study published in the journal Vaccines. They found that Long COVID prevalence was three to 10 times higher in individuals with three or more reported infections than in those with only one infection.

The Sick Times - Chronicling the Long Covid crisis (thesicktimes.org)
-
· Researchers in Spain assessed over 190,000 participants, found that #LongCOVID prevalence was three to 10 times higher in individuals with three or more reported infections
· A new RECOVER study published in JAMA found that olfactory dysfunction, or changes to sense of smell, occurred in people after SARS-CoV-2 infection
· A behavioral trial at Columbia University (LONG-CALM) is assessing a vague “mindfulness intervention” for Long COVID
Research updates, September 30 - The Sick Times
Researchers in Spain assessed over 190,000 participants, using data from a public health research network, in a study published in the journal Vaccines. They found that Long COVID prevalence was three to 10 times higher in individuals with three or more reported infections than in those with only one infection.

The Sick Times - Chronicling the Long Covid crisis (thesicktimes.org)
· A new study that found the risk of Long COVID doubled in children following SARS-C0V-2 reinfection made mainstream headlines this week
· Researchers in Japan may have found a potential biomarker and treatment target for cognitive dysfunction in #LongCOVID
· A new phase 1 clinical trial is currently recruiting to test the GLP-1 agonist drug Liraglutide for Long COVID, multiple sclerosis, and acute leukemia
Research updates, October 7 - The Sick Times
A new study that found the risk of Long COVID doubled in children following SARS-C0V-2 reinfection made mainstream headlines this week.

The Sick Times - Chronicling the Long Covid crisis (thesicktimes.org)
-
· A new study that found the risk of Long COVID doubled in children following SARS-C0V-2 reinfection made mainstream headlines this week
· Researchers in Japan may have found a potential biomarker and treatment target for cognitive dysfunction in #LongCOVID
· A new phase 1 clinical trial is currently recruiting to test the GLP-1 agonist drug Liraglutide for Long COVID, multiple sclerosis, and acute leukemia
Research updates, October 7 - The Sick Times
A new study that found the risk of Long COVID doubled in children following SARS-C0V-2 reinfection made mainstream headlines this week.

The Sick Times - Chronicling the Long Covid crisis (thesicktimes.org)
· A large electronic health records study found SARS-CoV-2 infection is associated with elevated risks of Human Papillomavirus (HPV)-related cancer
· A small study in the Journal of Translation Medicine found a potential blood test for myalgic encephalomyelitis (ME)
· Researchers have developed a device that may be able to accurately measure fibrinaloid microclots in children
Research updates, October 14 - The Sick Times
A large electronic health records study found SARS-CoV-2 infection is associated with elevated risks of Human Papillomavirus (HPV)-related cancer.

The Sick Times - Chronicling the Long Covid crisis (thesicktimes.org)
-
· A large electronic health records study found SARS-CoV-2 infection is associated with elevated risks of Human Papillomavirus (HPV)-related cancer
· A small study in the Journal of Translation Medicine found a potential blood test for myalgic encephalomyelitis (ME)
· Researchers have developed a device that may be able to accurately measure fibrinaloid microclots in children
Research updates, October 14 - The Sick Times
A large electronic health records study found SARS-CoV-2 infection is associated with elevated risks of Human Papillomavirus (HPV)-related cancer.

The Sick Times - Chronicling the Long Covid crisis (thesicktimes.org)
· A clinical trial for the anti-inflammatory drug Colchicine did not find the drug effective for #LongCOVID
· A white paper from the Patient-Led Research Collaborative assessed Long COVID in India
· Researchers recently critiqued the study design and conclusions of a controversial 2024 study on ME, which asserted that the disease was a result of altered “effort preference” and deconditioning
Research updates, October 21 - The Sick Times
A clinical trial for the anti-inflammatory drug Colchicine did not find the drug effective for Long COVID, according to a new study published in JAMA Internal Medicine. The randomized trial included 346 participants in India who took at least 0.5 milligrams once or twice per day, or a placebo, for 52 weeks.

The Sick Times - Chronicling the Long Covid crisis (thesicktimes.org)
-
· A clinical trial for the anti-inflammatory drug Colchicine did not find the drug effective for #LongCOVID
· A white paper from the Patient-Led Research Collaborative assessed Long COVID in India
· Researchers recently critiqued the study design and conclusions of a controversial 2024 study on ME, which asserted that the disease was a result of altered “effort preference” and deconditioning
Research updates, October 21 - The Sick Times
A clinical trial for the anti-inflammatory drug Colchicine did not find the drug effective for Long COVID, according to a new study published in JAMA Internal Medicine. The randomized trial included 346 participants in India who took at least 0.5 milligrams once or twice per day, or a placebo, for 52 weeks.

The Sick Times - Chronicling the Long Covid crisis (thesicktimes.org)
· A small mechanistic study in Frontiers in Immunology analyzed chronic inflammation in #COVID19.
· A recent paper found that low-dose rapamycin alleviated symptoms of fatigue and post-exertional malaise in people with #MECFS.
· A phase 2 clinical trial is recruiting in Boston, Massachusetts to test the drugs Pyridostigmine (Mestinon) and Low-Dose Naltrexone (LDN) for ME.

Research updates, October 28 - The Sick Times
A small mechanistic study in Frontiers in Immunology analyzed chronic inflammation in COVID-19. Researchers assessed over 70,000 blood cells from eight participants across different disease states.

The Sick Times - Chronicling the Long Covid crisis (thesicktimes.org)
-
· A small mechanistic study in Frontiers in Immunology analyzed chronic inflammation in #COVID19.
· A recent paper found that low-dose rapamycin alleviated symptoms of fatigue and post-exertional malaise in people with #MECFS.
· A phase 2 clinical trial is recruiting in Boston, Massachusetts to test the drugs Pyridostigmine (Mestinon) and Low-Dose Naltrexone (LDN) for ME.

Research updates, October 28 - The Sick Times
A small mechanistic study in Frontiers in Immunology analyzed chronic inflammation in COVID-19. Researchers assessed over 70,000 blood cells from eight participants across different disease states.

The Sick Times - Chronicling the Long Covid crisis (thesicktimes.org)
· The #German government is cutting millions of euros in #LongCOVID funding
· Large electronic cohort study from Sweden found that 1.4% of people with a documented #COVID19 case were officially diagnosed with Long COVID by medical providers
· Lidia Morawska, Australian scientist who alerted the world that SARS-CoV-2 was airborne, was recently recognized for her work with a prestigious science prize for “pioneering research about the air we breathe"
Research updates, November 4 - The Sick Times
The German government is cutting millions of euros in Long COVID funding, according to the German business newspaper Handelsblatt.

The Sick Times - Chronicling the Long Covid crisis (thesicktimes.org)
-
· The #German government is cutting millions of euros in #LongCOVID funding
· Large electronic cohort study from Sweden found that 1.4% of people with a documented #COVID19 case were officially diagnosed with Long COVID by medical providers
· Lidia Morawska, Australian scientist who alerted the world that SARS-CoV-2 was airborne, was recently recognized for her work with a prestigious science prize for “pioneering research about the air we breathe"
Research updates, November 4 - The Sick Times
The German government is cutting millions of euros in Long COVID funding, according to the German business newspaper Handelsblatt.

The Sick Times - Chronicling the Long Covid crisis (thesicktimes.org)
· The RECOVER-NEURO clinical trial found that “cognitive rehabilitation” failed in treating #LongCOVID
· Scientists are revealing more about microclots and Long COVID. A recent study in the Journal of Medical Virology found a strong association between microclots and net-like structures that some white blood cells (called neutrophils) release to attack pathogens
· A study about #MECFS was retracted by the journal Food Science and Nutrition
Research updates, November 11 - The Sick Times
The RECOVER-NEURO clinical trial found that “cognitive rehabilitation” failed in treating Long COVID. The National Institutes of Health (NIH) study included 328 people who underwent interventions of either online cognitive training (computer games), a cognitive rehabilitation program, or received electric currents on their heads.

The Sick Times - Chronicling the Long Covid crisis (thesicktimes.org)
-
· The RECOVER-NEURO clinical trial found that “cognitive rehabilitation” failed in treating #LongCOVID
· Scientists are revealing more about microclots and Long COVID. A recent study in the Journal of Medical Virology found a strong association between microclots and net-like structures that some white blood cells (called neutrophils) release to attack pathogens
· A study about #MECFS was retracted by the journal Food Science and Nutrition
Research updates, November 11 - The Sick Times
The RECOVER-NEURO clinical trial found that “cognitive rehabilitation” failed in treating Long COVID. The National Institutes of Health (NIH) study included 328 people who underwent interventions of either online cognitive training (computer games), a cognitive rehabilitation program, or received electric currents on their heads.

The Sick Times - Chronicling the Long Covid crisis (thesicktimes.org)
· New mechanistic study in Science Translational Medicine identifies Epstein-Barr virus as a potential trigger of the autoimmune disease systemic #lupus erythematosus
· Michael Peluso of UCSF shared updates on two upcoming #LongCOVID trials:
- One potential trial called COMBAT-LC plans to test the combination of the monoclonal antibody Pemgarda with the antiviral Paxlovid
- The second trial INTERRUPT-LC will test the bladder cancer drug Anktiva
Research updates, November 18 - The Sick Times
A new mechanistic study in Science Translational Medicine identifies Epstein-Barr virus (EBV) as a potential trigger of the autoimmune disease systemic lupus erythematosus.

The Sick Times - Chronicling the Long Covid crisis (thesicktimes.org)
-
· New mechanistic study in Science Translational Medicine identifies Epstein-Barr virus as a potential trigger of the autoimmune disease systemic #lupus erythematosus
· Michael Peluso of UCSF shared updates on two upcoming #LongCOVID trials:
- One potential trial called COMBAT-LC plans to test the combination of the monoclonal antibody Pemgarda with the antiviral Paxlovid
- The second trial INTERRUPT-LC will test the bladder cancer drug Anktiva
Research updates, November 18 - The Sick Times
A new mechanistic study in Science Translational Medicine identifies Epstein-Barr virus (EBV) as a potential trigger of the autoimmune disease systemic lupus erythematosus.

The Sick Times - Chronicling the Long Covid crisis (thesicktimes.org)
· A review paper summarizes the vast global costs of #LongCOVID, it is estimated to have an average annual burden of at least $1 trillion globally per year
· A small study in Nature found SARS-CoV-2 in the organs of fetuses from people who were infected with the virus while pregnant
· The National Institutes of Health’s RECOVER-Treating Long COVID initiative released a draft of its protocol for the low-dose naltrexone trial for people ages 6-25
Research updates, November 25 - The Sick Times
A new review paper summarizes the vast global costs of Long COVID. Public health researcher Amit Bansal from the University of Bergen conducted an economic literature analysis and determined that Long COVID is estimated to have an average annual burden of at least $1 trillion globally each year.

The Sick Times - Chronicling the Long Covid crisis (thesicktimes.org)
-
· A review paper summarizes the vast global costs of #LongCOVID, it is estimated to have an average annual burden of at least $1 trillion globally per year
· A small study in Nature found SARS-CoV-2 in the organs of fetuses from people who were infected with the virus while pregnant
· The National Institutes of Health’s RECOVER-Treating Long COVID initiative released a draft of its protocol for the low-dose naltrexone trial for people ages 6-25
Research updates, November 25 - The Sick Times
A new review paper summarizes the vast global costs of Long COVID. Public health researcher Amit Bansal from the University of Bergen conducted an economic literature analysis and determined that Long COVID is estimated to have an average annual burden of at least $1 trillion globally each year.

The Sick Times - Chronicling the Long Covid crisis (thesicktimes.org)
· Large retrospective cohort study of over 18,000 births found infants exposed to #COVID19 during pregnancy were more likely to have adverse neurodevelopmental diagnoses as 3 years olds
· Another study has found that common diabetes drug metformin may help reduce risk of #LongCOVID
· NIH is recruiting for a small observational study to understand if people with neurological symptoms of Long COVID have inactive [?] remnants of SARS-CoV-2 in their bodies
Research updates, December 2 - The Sick Times
A large retrospective cohort study of over 18,000 live births found that infants exposed to SARS-CoV-2 infection during pregnancy were more likely to have adverse neurodevelopmental diagnoses by the time they were three years old.

The Sick Times - Chronicling the Long Covid crisis (thesicktimes.org)
-
· Large retrospective cohort study of over 18,000 births found infants exposed to #COVID19 during pregnancy were more likely to have adverse neurodevelopmental diagnoses as 3 years olds
· Another study has found that common diabetes drug metformin may help reduce risk of #LongCOVID
· NIH is recruiting for a small observational study to understand if people with neurological symptoms of Long COVID have inactive [?] remnants of SARS-CoV-2 in their bodies
Research updates, December 2 - The Sick Times
A large retrospective cohort study of over 18,000 live births found that infants exposed to SARS-CoV-2 infection during pregnancy were more likely to have adverse neurodevelopmental diagnoses by the time they were three years old.

The Sick Times - Chronicling the Long Covid crisis (thesicktimes.org)
· A new study in the International Journal of Infectious Diseases examines how #COVID19 impacts the immune system
· German government announced just over €500 million ($582 million USD) in funding for infection-associated diseases, including #LongCOVID & #MECFS
· A preprint using data from the DecodeME study found more than 250 genes associated with ME, 76 of which were shared with Long COVID
Research updates, December 9 - The Sick Times
A new study in the International Journal of Infectious Diseases examines how COVID-19 impacts the immune system.

The Sick Times - Chronicling the Long Covid crisis (thesicktimes.org)
-
· A new study in the International Journal of Infectious Diseases examines how #COVID19 impacts the immune system
· German government announced just over €500 million ($582 million USD) in funding for infection-associated diseases, including #LongCOVID & #MECFS
· A preprint using data from the DecodeME study found more than 250 genes associated with ME, 76 of which were shared with Long COVID
Research updates, December 9 - The Sick Times
A new study in the International Journal of Infectious Diseases examines how COVID-19 impacts the immune system.

The Sick Times - Chronicling the Long Covid crisis (thesicktimes.org)
· New study in Cureus found veterans diagnosed with #LongCOVID at 34% higher risk of visiting emergency department 6 months after infection
· “Our data demonstrate that [LC] is characterized by chronic inflammation, immune exhaustion, & metabolic dysregulation,” scientists conclud in new study published in Nature Immunology
· U.K. charity ME Association awards £1.1 million in funding to the Imperial College to study immunological profiles of LC & #MECFS
Research updates, December 16 - The Sick Times
A new observational study in Cureus found that veterans diagnosed with Long COVID had a 34% higher risk of visiting the emergency department (ED) six months following infection than those without Long COVID.

The Sick Times - Chronicling the Long Covid crisis (thesicktimes.org)
-
· New study in Cureus found veterans diagnosed with #LongCOVID at 34% higher risk of visiting emergency department 6 months after infection
· “Our data demonstrate that [LC] is characterized by chronic inflammation, immune exhaustion, & metabolic dysregulation,” scientists conclud in new study published in Nature Immunology
· U.K. charity ME Association awards £1.1 million in funding to the Imperial College to study immunological profiles of LC & #MECFS
Research updates, December 16 - The Sick Times
A new observational study in Cureus found that veterans diagnosed with Long COVID had a 34% higher risk of visiting the emergency department (ED) six months following infection than those without Long COVID.

The Sick Times - Chronicling the Long Covid crisis (thesicktimes.org)
· Two recent studies state that #LongCOVID is an occupational disease.
· Vanderbilt researchers are conducting an immune profiling study on people with Long COVID and postural orthostatic tachycardia syndrome (#POTS)
· A new phase two remote clinical trial was recently announced for myalgic encephalomyelitis (ME) #MECFS
Research updates, December 23 - The Sick Times
Two recent studies state that Long COVID is an occupational disease.

The Sick Times - Chronicling the Long Covid crisis (thesicktimes.org)
